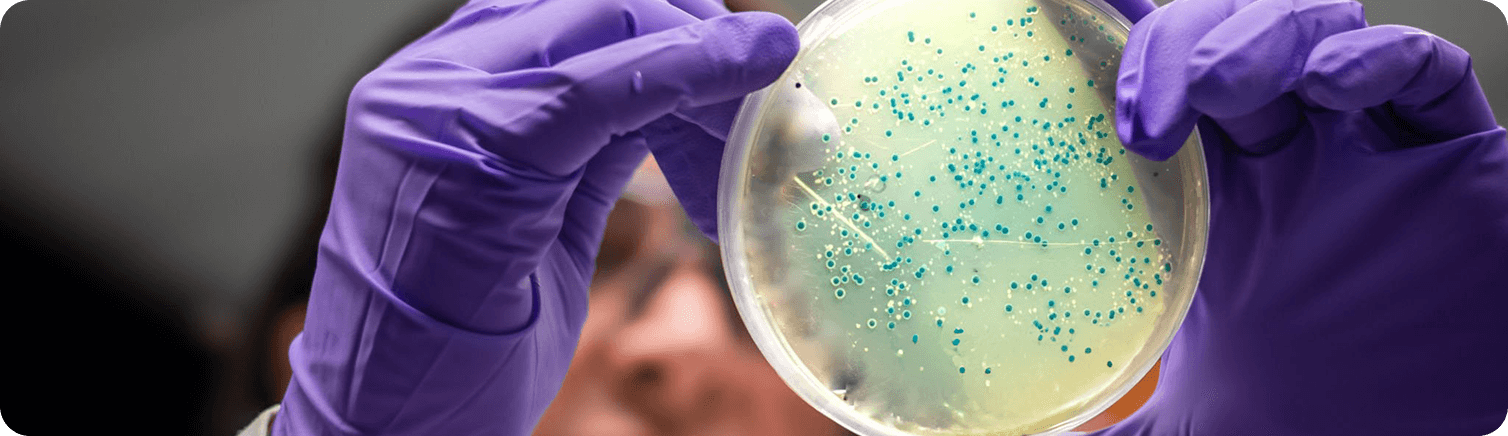

Votre panier est actuellement vide !
Labco, partenaire de confiance
+40 ans d’expérience
1906
Création du Service Technique de l’ACLCCP
1997
Accréditation par le COFRAC sur la microbiologie alimentaire
2021
Obtention de la certification QUALIOPI
2009
Début des analyses physico-chimie des produits laitiers et plats cuisinés

1
Qui sommes-nous ?
Le LABCO (Laboratoire d’Analyses du Centre-Ouest), était à l’origine le Service Technique de l’ACLCCP (Association Centrale des Laiteries Coopératives). Situé à Surgères (17), il compte deux unités techniques : microbiologie et chimie. À sa création, toutes les analyses étaient produites au service de la filière laitière.
N’ayant cessé de se développer et d’évoluer vers des techniques d’analyses de plus en plus fines, le LABCO est depuis de nombreuses années au service de différentes filières du secteur de l’agroalimentaire : industries alimentaires, laitières, alimentation animale, eaux…
Accrédité par le COFRAC, le laboratoire est soumis à des audits de surveillance et de renouvellement, impliquant une traçabilité et un suivi permanent des analyses.
Le LABCO est aujourd’hui juridiquement indépendant de l’ACLCCP.
2
Microbiologie
Le service microbiologie du LABCO joue un rôle essentiel dans la sécurité sanitaire des aliments. Il se consacre à l’étude des micro-organismes présents dans les denrées alimentaires, qu’ils soient bénéfiques (comme les ferments lactiques) ou pathogènes (tels que Listeria monocytogenes, Salmonella, Escherichia coli, Staphylocoques, STEC, Entérotoxines, virus, etc.).
Ces micro-organismes peuvent contaminer les produits à toutes les étapes de la chaîne de production, du champ à l’assiette. Le service microbiologie a donc pour mission de :
- Détecter et quantifier les agents pathogènes et les flores d’altération.
- Évaluer l’hygiène des procédés de fabrication via des contrôles de surface et d’environnement.
- Valider la conformité réglementaire des produits selon les critères définis par les règlements européens (CE 2073/2005, CE 852/2004) et les normes ISO 17025.
- Accompagner les industriels dans la mise en œuvre de leur Plan de Maîtrise Sanitaire (PMS), leur plan d’autocontrôle, et leurs audits qualité.

3
Chimie
Le service de chimie regroupe deux spécialités complémentaires : la chimie alimentaire, centrée sur les produits destinés à la consommation, et la chimie des eaux, dédiée à la qualité des eaux utilisées ou rejetées.
La chimie alimentaire analyse la composition des produits agroalimentaires pour garantir leur qualité nutritionnelle et leur conformité réglementaire. Elle permet de mesurer les nutriments (protéines, lipides, glucides…), de détecter les contaminants chimiques (allergènes, mycotoxines…), de vérifier et valider l’étiquetage nutritionnel, de rechercher la fraude (tests d’adultération et de spéciation)
L’eau doit être contrôlée avec rigueur. Le LABCO dispose des moyens techniques et humains pour garantir sa qualité.
- Eaux chaudes sanitaires : contrôle annuel obligatoire (Légionelle) pour hôtels, EHPAD, crèches, hôtellerie de plein air… avec prélèvements sur site par nos techniciens.
- Eaux de consommation : analyses physico-chimiques et microbiologiques sur puits, , réseaux, forages.
- Eaux résiduaires : contrôle des rejets industriels et épandages, accompagnement réglementaire face aux exigences croissantes.

4
Service aux clients
Au sein du LABCO, notre service dédié aux prélèvements chez nos clients assure une prise en charge personnalisée et professionnelle directement sur site. Nos techniciens se déplacent chez vous, clients, pour réaliser les prélèvements nécessaires dans le respect des protocoles sanitaires et réglementaires en vigueur.
Cette approche permet de garantir une réactivité optimale, une traçabilité rigoureuse des échantillons et un confort accru pour nos partenaires, tout en maintenant les standards de qualité élevés qui font la réputation de notre laboratoire d’analyses.

5
Formation Acc. qualité
Parce que la maîtrise des risques passe par la connaissance et l’évaluation, le LABCO s’engage à vos côtés pour renforcer la qualité et la sécurité sanitaire de vos activités.
À travers des formations professionnelles sur-mesure (certification Qualiopi) et des audits personnalisés, nous vous accompagnons dans vos enjeux réglementaires et opérationnels.
Notre approche pédagogique rigoureuse, nos outils d’analyse performants et notre expertise terrain font de chaque intervention une opportunité d’amélioration continue.
Faites de vos obligations un levier de performance durable.



















